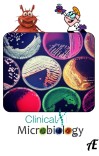
Practical Clinical Microbiology cover image

Books
334 books found
Categories

د نرسنګ تطبيقات

هایپوګلیسیمیا (Hypoglycemia)

د اندوکراین سیستم Endocrine System

د زړه اناټومې Heart Anatomy

Vitamins

د لوړ فشار ضد درمل

CNS System Drugs

زهر شناسی عمومی

Urology for Medical Students and Junior Doctors

Anesthesia drugs dose

تسلیمه کاکړ د التراسونډ اسانه زده کړه